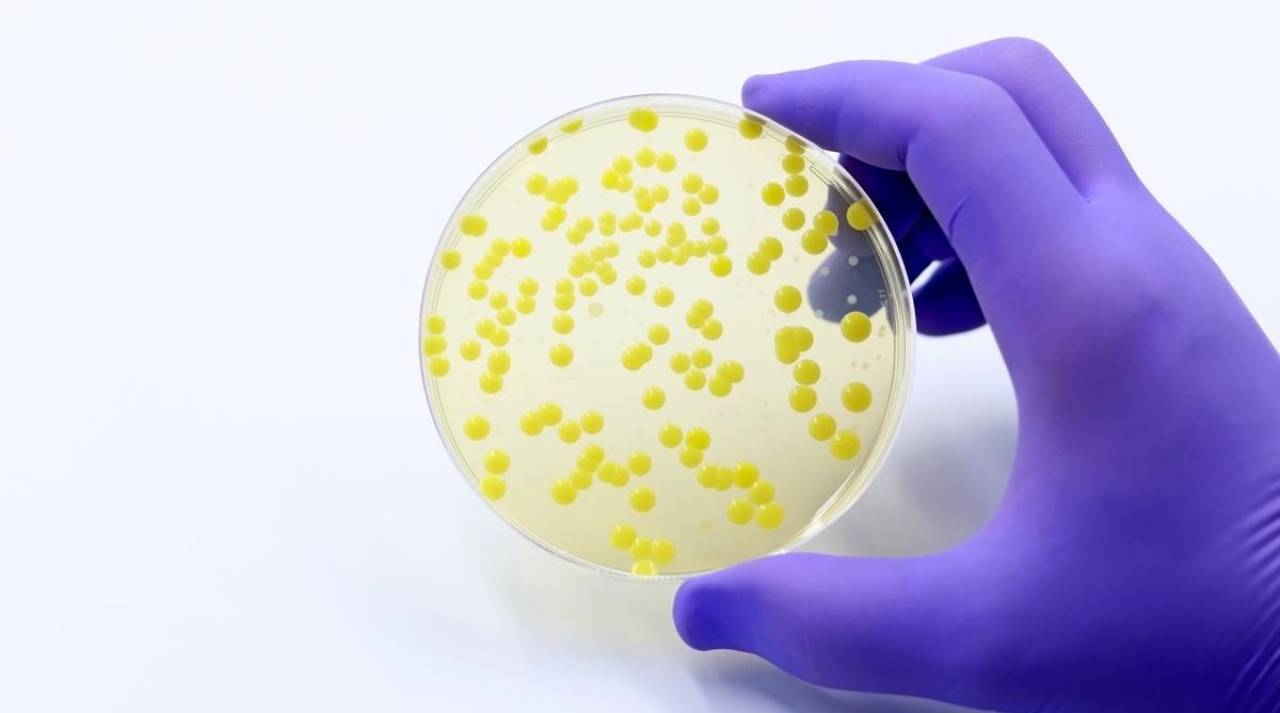

Tháng 9, 2025
- 27 Tháng 9
Các quan chức y tế cảnh báo sự gia tăng của loại vi khuẩn kháng thuốc nguy hiểm
Trong những năm gần đây, tại Việt Nam và nhiều quốc gia trên thế giới đã có "sự gia tăng đáng kể” của một chủng vi khuẩn kháng thuốc nguy hiểm. Ibuprofen và Paracetamol; 2…
- 19 Tháng 9
Ibuprofen và Paracetamol – 2 loại thuốc phổ biến có liên quan đến kháng kháng sinh
Ibuprofen và acetaminophen (paracetamol) từ lâu là những loại thuốc được sử dụng rộng rãi tại Việt Nam và nhiều nước trên thế giới. Tuy nhiên, nghiên cứu mới công bố ngày 25/8/2025 cho thấy…
Tháng 8, 2024
- 11 Tháng 8
Kháng kháng sinh sẽ gây tử vong nhiều hơn ung thư, và điều này không thể tránh được
Ước tính đến năm 2025, kháng kháng sinh là nguyên nhân tử vong lớn hơn cả ung thư trên toàn cầu. Việc đề kháng kháng sinh là không thể tránh được, nếu con người tiếp…
Tháng 2, 2020
- 4 Tháng 2
Phù chính, khu tà: Triết lý dưỡng sinh Đông – Tây hội ngộ, cứu nguy thời thế
Khoa học hiện đại đưa ra bằng chứng về mối liên hệ mật thiết giữa tinh thần và sức khỏe, triết lý dưỡng sinh Đông - Tây hội ngộ...
Tháng 4, 2018
- 7 Tháng 4
Phát hiện siêu vi khuẩn “ác mộng” ở 27 bang của Mỹ
Loại vi khuẩn này có tên là carbapenem-resistant Enterobacteriaceae, viết tắt là CRE. Nó có thể gây viêm phổi, viêm nhiễm máu. Tỷ lệ tử…
Tháng 9, 2017
- 26 Tháng 9
Thuốc Đông y kháng khuẩn không cao, vì sao lại chữa được bệnh nhiễm trùng?
Theo y học hiện đại, muốn diệt các bệnh nhiễm trùng thì cần dùng thuốc kháng sinh. Tuy nhiên, trong Đông y, các thuốc thanh nhiệt giải độc có tính kháng khuẩn rất nhẹ nhưng vẫn trị được nhiều bệnh kiểu này. Vì sao? Thuốc …
Tháng 6, 2017
- 24 Tháng 6
Xà phòng diệt khuẩn không sạch hơn hay tốt hơn: FDA cấm sau hơn 30 năm sử dụng
Dựa trên quan niệm rằng vi khuẩn, vi trùng là thủ phạm gây ra bệnh tật, rất nhiều sản phẩm tẩy rửa có chứa chất diệt khuẩn đã ra đời. Tuy nhiên, sau hàng chục năm sử dụng các nhà nghiên cứu đã thấy rằng …
Tháng 1, 2017
- 16 Tháng 1
Mua thịt, cá, trứng thời nay, bạn sẽ “được” cả kháng sinh!
Kháng kháng sinh không phải là vấn đề có thể xem nhẹ. Những người làm trong ngành y tế đều đã hết lời cảnh báo về sự nguy hiểm của nó.
- 7 Tháng 1
Các bác sĩ bây giờ bất lực nhiều lắm…
Các bác sĩ bây giờ bất lực nhiều lắm… Không tin, bạn có thể nhìn vào ảnh bên dưới. Đây là ảnh chụp kết quả kháng sinh đồ của một bệnh nhân trong thành phố Hồ Chí Minh. Có thể thấy rằng loại vi khuẩn …
Tháng 12, 2016
- 10 Tháng 12
Các bác sĩ đã có thể lọc vi khuẩn trong máu nhờ… nam châm
Công nghệ mới dưới đây cho phép các bác sĩ có thể lọc thành công vi khuẩn trong máu bằng nam châm, mà không cần dùng đến thuốc kháng sinh. Nhiểm khuẩn huyết hay nhiễm trùng máu không phải là trò đùa. Hơn một nửa …
- 7 Tháng 12
EDCD cảnh báo: Hàng phòng thủ kháng sinh cuối cùng đang bắt đầu tan rã
Theo Trung tâm Ngăn ngừa và Kiểm soát Dịch bệnh (CDC) của Mỹ, hằng năm có khoảng 2 triệu người bị nhiễm vi khuẩn kháng tất cả các loại thuốc kháng sinh mà con người đang có, và trong đó ít nhất 23.000 người đã …
Tháng 9, 2016
- 27 Tháng 9
Liên Hiệp Quốc họp bàn về ‘kháng kháng sinh’ – cơn đại dịch của tương lai
“Vấn đề kháng kháng sinh gây ra mối đe dọa nền tảng nghiêm trọng cho sức khỏe con người, sự phát triển và an ninh xã hội” – Tiến sĩ Margaret Chan, Chủ tịch WHO cho biết. Theo CNN đưa tin, phiên họp lần thứ 71 của Đại hội đồng Liên Hiệp Quốc …
- 15 Tháng 9
Video thí nghiệm: Vi khuẩn phát triển thành siêu vi khuẩn chỉ trong 11 ngày
Các nhà khoa học Harvard đã làm một đĩa cấy vi khuẩn khổng lồ rồi xem chúng phát triển như thế nào trong môi trường thuốc kháng sinh ngày càng đậm đặc. Thí nghiệm với…